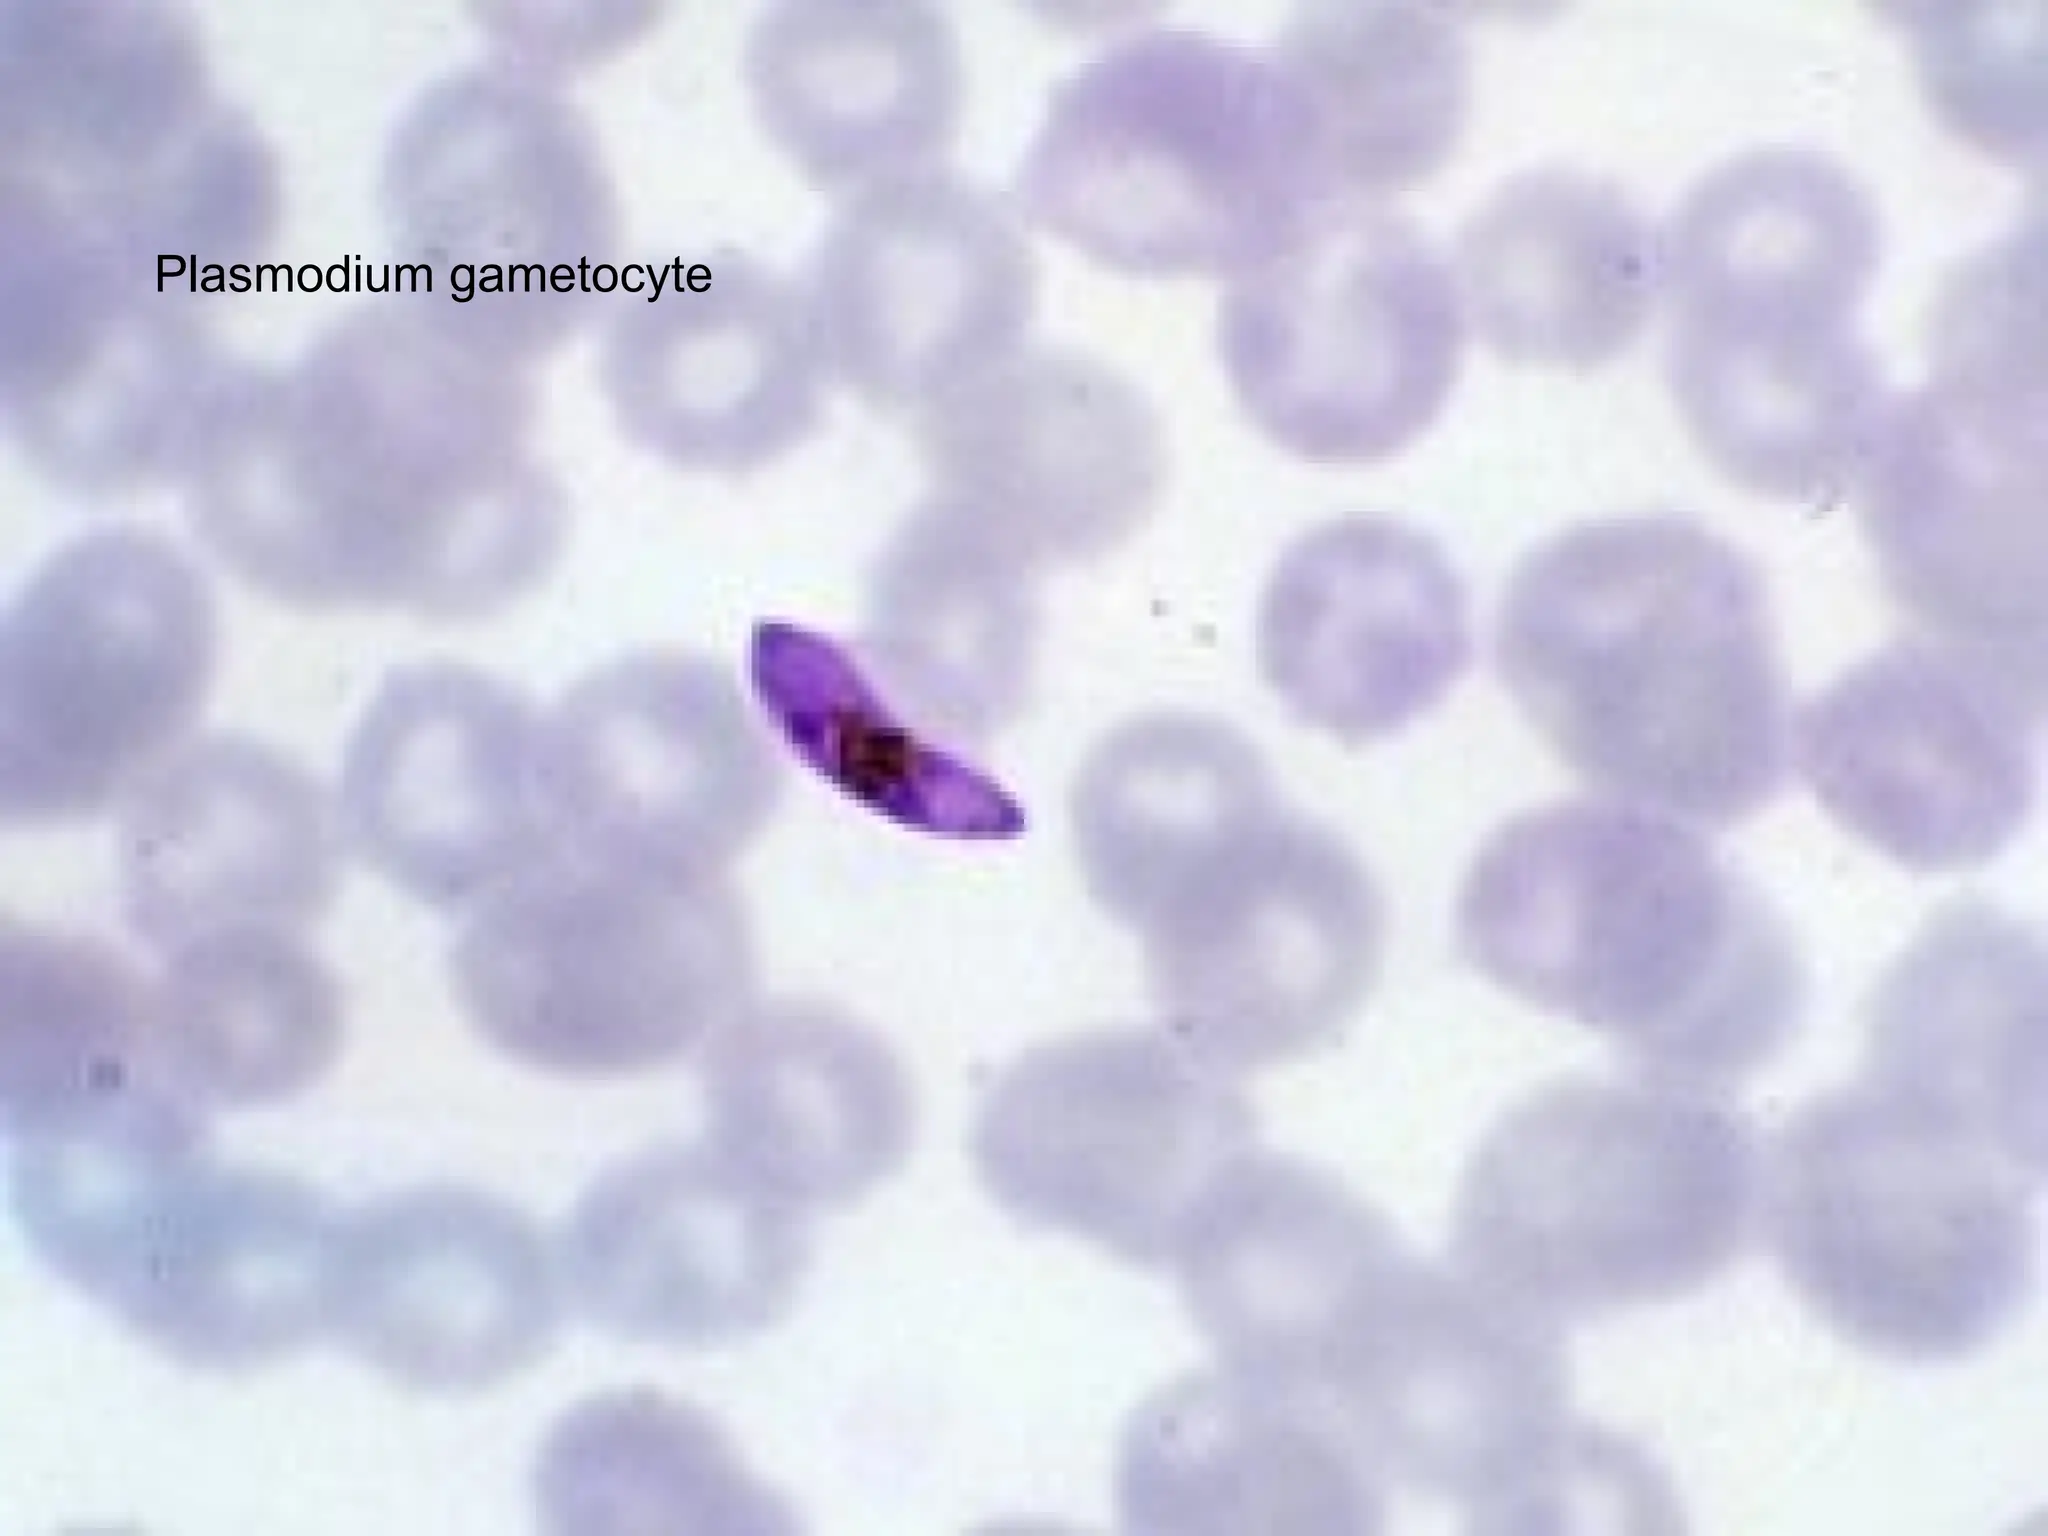
Plasmodium gametocyte
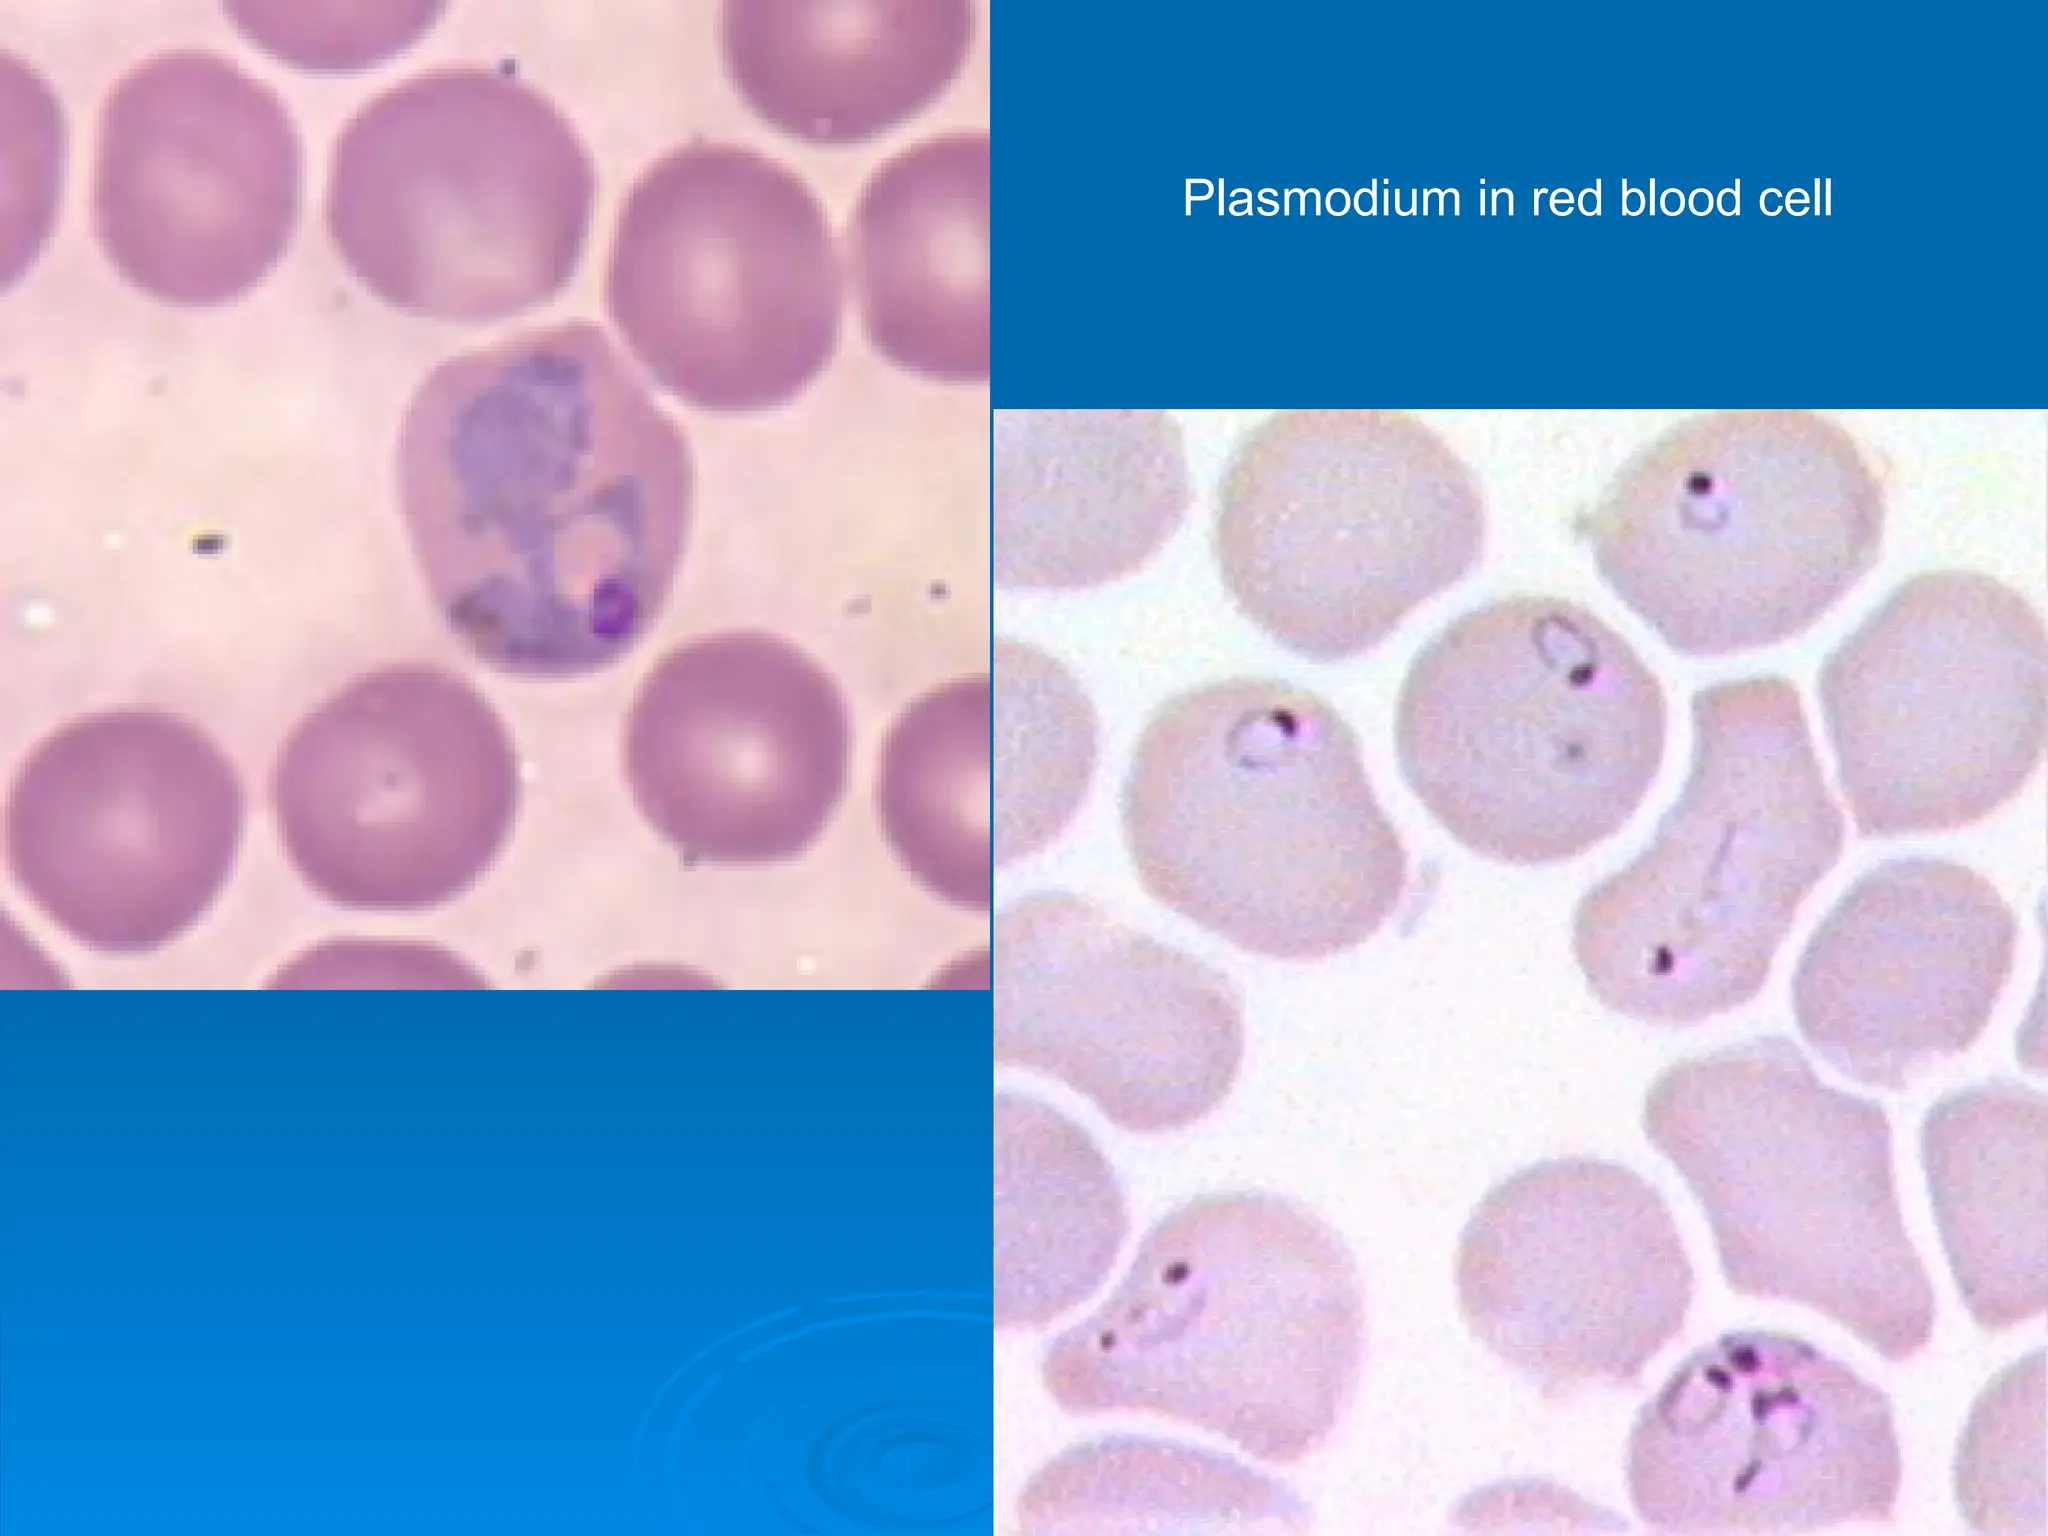
Plasmodium in red blood cell

Protozoans are unicellular eukaryotes that lack a cell wall and exhibit complex cellular structures with various organelles. They can be autotrophic or heterotrophic, reproduce both asexually and sexually, and are categorized into at least seven phyla. Protozoa are implicated in diseases like malaria, which is caused by the Plasmodium parasite, transmitted by mosquitoes, leading to significant morbidity and mortality worldwide.